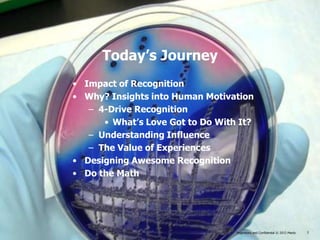
Today’s Journey
• Impact of Recognition
• Why? Insights into Human Motivation
   – 4-Drive Recognition
      • What’s Love Got to Do With It?
   – Understanding Influence
   – The Value of Experiences
• Designing Awesome Recognition
• Do the Math




                                    Proprietary and Confidential © 2013 Maritz
                                 Proprietary and Confidential © 2013 Maritz      2

Michelle Pokorny gave a presentation on employee engagement and recognition. She discussed how recognition drives engagement and performance, citing various studies. She explained how meaningful reward and recognition can boost employee endorsement, motivation, and retention. Pokorny also covered insights into human motivation from neuroscience research, highlighting how recognition satisfies multiple human drives and releases the "trust hormone" oxytocin. Finally, she offered tips for designing impactful recognition programs, measuring their success, and calculating their return on investment through improved productivity and retention.